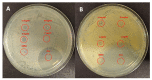

Inherently Antimicrobial P(MMA- ran-DMAEMA) Copolymers Sensitive to Photodynamic Therapy: A Double Bactericidal Effect for Active Wound Dressing
- PMID: 36901769
- PMCID: PMC10001570
- DOI: 10.3390/ijms24054340
Inherently Antimicrobial P(MMA- ran-DMAEMA) Copolymers Sensitive to Photodynamic Therapy: A Double Bactericidal Effect for Active Wound Dressing
Abstract
In this work, two compounds belonging to the BODIPY family, and previously investigated for their photosensitizing properties, have been bound to the amino-pendant groups of three random copolymers, with different amounts of methyl methacrylate (MMA) and 2-(dimethylamino)ethyl methacrylate (DMAEMA) in the backbone. The P(MMA-ran-DMAEMA) copolymers have inherently bactericidal activity, due to the amino groups of DMAEMA and to the quaternized nitrogens bounded to BODIPY. Systems consisting of filter paper discs coated with copolymers conjugated to BODIPY were tested on two model microorganisms, Escherichia coli (E. coli) and Staphylococcus aureus (S. aureus). On solid medium, irradiation with green light induced an antimicrobial effect, visible as a clear inhibition area around the coated disks. The system based on the copolymer with 43% DMAEMA and circa 0.70 wt/wt% of BODIPY was the most efficient in both bacterial species, and a selectivity for the Gram-positive model was observed, independently of the conjugated BODIPY. A residual antimicrobial activity was also observed after dark incubation, attributed to the inherently bactericidal properties of copolymers.
Keywords: BODIPY; antimicrobial materials; antimicrobial photodynamic therapy (aPDT); photoinactivation; photosensitizers.
Conflict of interest statement
The authors declare no conflict of interest.
Figures

References
-
- Templer S.J., Brito M.O. Bacterial skin and soft tissue infections. Hospital Phys. 2009;26:9–16.
MeSH terms
Substances
LinkOut - more resources
Full Text Sources
Molecular Biology Databases
Miscellaneous

